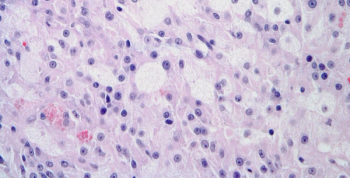

Twelve US lawmakers have asked the Obama administration to scrutinize the pricing of the prostate cancer agent enzalutamide and to consider licensing its generic production.

Your AI-Trained Oncology Knowledge Connection!


Twelve US lawmakers have asked the Obama administration to scrutinize the pricing of the prostate cancer agent enzalutamide and to consider licensing its generic production.

Men who receive pharmacologic androgen deprivation therapy as part of their treatment for prostate cancer may be at higher risk for depression.

Results of a phase II randomized trial found that combining a short course of androgen deprivation therapy with bevacizumab improved relapse-free survival in men with hormone-sensitive prostate cancer.

Researchers at UCLA are reporting that prostate adenocarcinoma and neuroendocrine prostate cancer can arise from a common epithelial clone.

A study published in Nature Medicine reports that suppressing the nuclear receptor protein ROR-γ with small-molecule compounds may reduce AR levels in CRPC and stop tumor growth.

Using simulation modeling, researchers found that PSA screening can be cost-effective if men with low-risk prostate cancer do not undergo treatment and if clinicians use restrictive criteria to make a decision to biopsy.

The diabetes drug pioglitazone was associated with an increased risk for bladder cancer among patients with type 2 diabetes, according to the results of a new study.

Targeted therapies have offered striking improvements in survival rates among white patients who are diagnosed with clear cell renal cell carcinoma (ccRCC) in recent years, but survival rates for African Americans have not budged.

The phase III HYPRO study failed to prove the non-inferiority of using hypofractionated radiotherapy compared with fractionated radiotherapy for late genitourinary and gastrointestinal toxicity in men with intermediate- or high-risk prostate cancer.

A 58-year-old man presents with symptoms of dysuria and a prostate biopsy is performed. What is your diagnosis?

The American Society of Clinical Oncology endorsed the European Association of Urology’s treatment guideline on muscle-invasive and metastatic bladder cancer.

The US Food and Drug Administration has accepted the priority application for atezolizumab (MPDL3280A), an investigational targeted agent for patients with locally advanced or metastatic urothelial carcinoma.

This article provides a comprehensive and up-to-date review of the role of HPV infections in men and in the development of penile cancer.

Our commentary aims to expand on the evolution and present state of the art in the pathology of HPV in penile cancer and precancerous lesions.

Over the past 5 years, several studies have investigated the molecular profiling of penile carcinomas, examining both genomic and epigenetic alterations. These studies have revealed distinct molecular pathways associated with HPV status.

Men who receive radiation therapy as treatment for their prostate cancer may have an increased risk of developing a secondary cancer, according to a meta-analysis of observational studies.

Analyses from the phase III ALSYMPCA trial showed that treatment with radium-223 resulted in quality-of-life improvements over placebo in patients with castration-resistant prostate cancer and symptomatic bone metastases.

The addition of ramucirumab to docetaxel improved progression-free survival compared with docetaxel alone in a randomized phase II trial of patients with locally advanced or metastatic urothelial carcinoma.

In light of the recent announcement by Vice President Joe Biden to infuse the US cancer research program with $1 billion, a so-called “Moon Shot” program, we are speaking today with Giulio Draetta, a clinician and cancer researcher at MD Anderson Cancer Center at the University of Texas in Houston, who leads that center’s Moon Shots program.

A panel of experts at the ASCO have reviewed and endorsed Cancer Care Ontario’s guideline on Active Surveillance for the Management of Localized Prostate Cancer.

Abituzumab did not extend progression-free survival in patients with castration-resistant prostate cancer, though it did improve bone lesion progression.

We present a joint perspective from the medical oncology and urologic disciplines on the ongoing efforts to advance clinical trial performance in order to discover new therapies for this fatal disease.

The great strength of the PCWG3 is the recognition that second- , third- , and fourth-line treatments offer new possibilities for extending overall survival.

The 2012 change in guidelines regarding PSA testing for prostate cancer had a different effect on testing rates depending on which physician specialty was doing the testing.
A 23-year-old young man presents with a testicular lesion. After assessing the lesion, a biopsy is performed. What is your diagnosis?